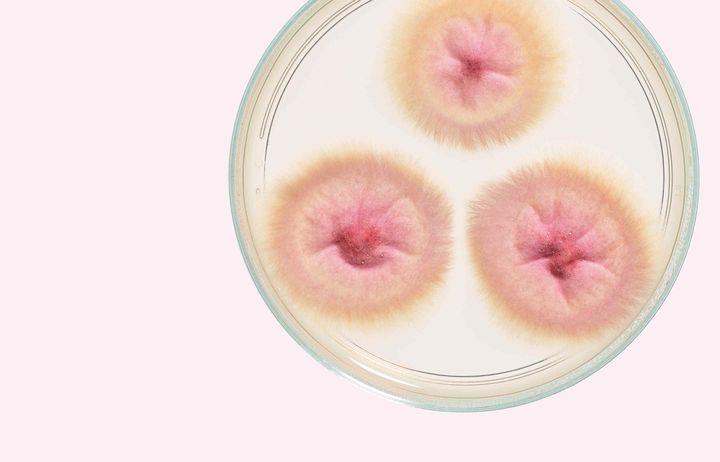

Imperial/47: Winter 2019–20
In this issue
We learn about Professor Peter Allison's passion for rocks, hear from alumni about what's behind their choice of career in the world of politics, and visit medical student, Arian Arjomandi Rad's favourite spot, Hyde Park. We also explore the fight to protect us from antifungal resistance, Imperial's role in the hunt for a cure for HIV and whether bots could help to combat the spread of fake news.